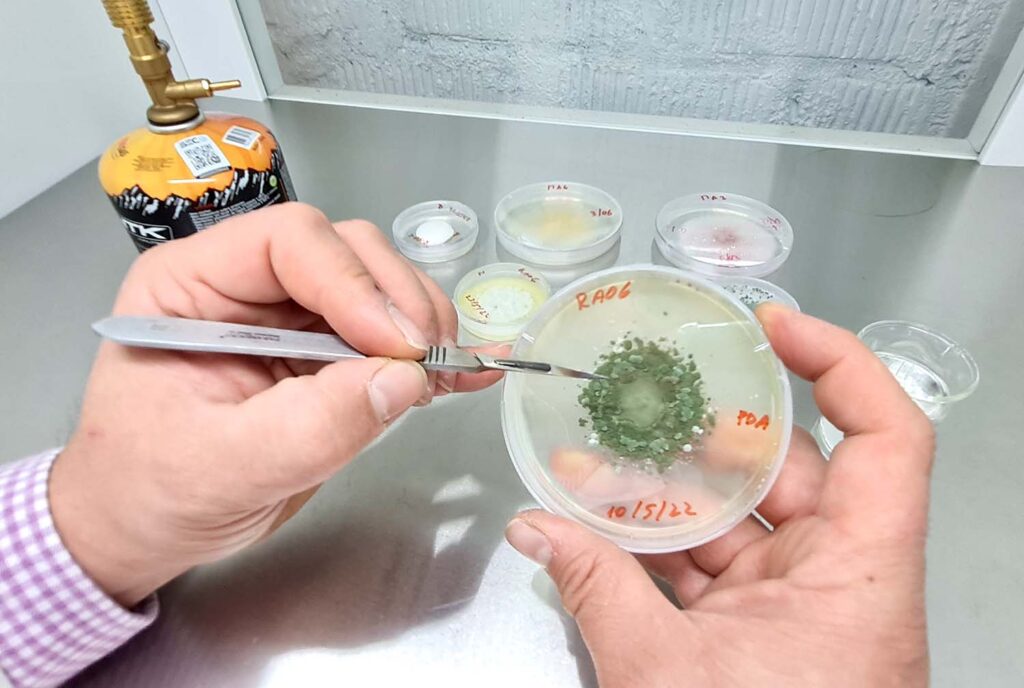

Jóvenes investigadores viajarán a la Antártica para encontrar hongos que podrían controlar el Alzheimer
Se trata de los doctores Jaime R. Cabrera Pardo (38) y Ramón Ahumada Rudolph (37), ambos académicos del Departamento de Química de la Universidad del Bío-Bío, quienes preparan su viaje para enero de 2023.

Encontrar moléculas en hongos en la Antártica que controlen el Alzheimer, será la misión de los investigadores del Departamento de Química de la Universidad del Bío-Bío (UBB), Jaime R. Cabrera Pardo y Ramón Ahumada Rudolph, quienes en enero de 2023 viajarán para recolectar las muestras en la región más austral de Chile.
La idea de esta investigación es la posibilidad de aislar microorganismos que habitan en condiciones extremas e inexploradas que ofrece la Antártica, los que producen moléculas con características y potencialidad únicas.
Las enfermedades neurodegenerativas son unos de los retos socio-sanitarios de la actualidad, siendo el Alzheimer una de las más prevalentes. Esta patología se caracteriza por un deterioro cerebral, que culmina con un daño cognitivo y trastornos del comportamiento.
El doctor en Química Orgánica de la Universidad de Chicago (USA, Fulbright Fellow) y Postdoctorado en la Universidad de Cambridge (UK, Marie Curie Fellow), Jaime R. Cabrera Pardo, señala que “actualmente la comunidad científica está reuniendo esfuerzos para desarrollar nuevos compuestos naturales efectivos, con el fin de retrasar el inicio y desarrollo del Alzheimer, junto a otras patologías neurodegenerativas”.
Agrega que “se ha demostrado que algunos hongos de zonas prístinas y condiciones extremófilas de la Antártica tienen un alto potencial de ejercer un efecto neuroprotector, lo que constituye una gran reserva de posibles fármacos y agentes nutracéuticos”.
Se estima que a nivel global, sobre 40 millones de personas padecen algún tipo de demencia. La prevalencia de esa enfermedad en la población chilena total es de alrededor del 1%, cifra que sube cercano al 7% en la población mayor a 60 años de edad.
El trabajo que viene
Durante 12 días los investigadores recolectarán distintas muestras, como sustratos vegetales, suelo, sedimentos y agua de mar, las que se irán procesando en el laboratorio microbiológico de la Base Científica Profesor Julio Escudero, ubicada en la Antártica y que es administrada por el Instituto Antártico Chileno (INACH).
Posteriormente, con los hongos extremófilos aislados en la Antártica, se les realizará un estudio de secuencia genética, para analizar sus nucleótidos y comparar con la base mundial de datos Genbank, que reúne más de 2.450 millones de cepas con registro de identificación o si corresponde a una nueva especie.
El doctor en Ciencias Ambientales de la Universidad de Concepción y Post-Doctorado Universidad del Bío- Bío y Fondef-Idea, Ramón Ahumada Rudolph, dijo que “en un periodo de 3 años, nuestra investigación buscará en nuestro Laboratorio de Química Aplicada y Sustentable – labQAS, metabolitos secundarios obtenidos desde ecosistemas antárticos, donde realizaremos ensayos antioxidantes, antimicrobianos, inmunomodulares, celulares y principalmente neuro-protectoras, para descubrir moléculas activas que puedan generar con éxito su actividad farmacológica a nivel de laboratorio”.

